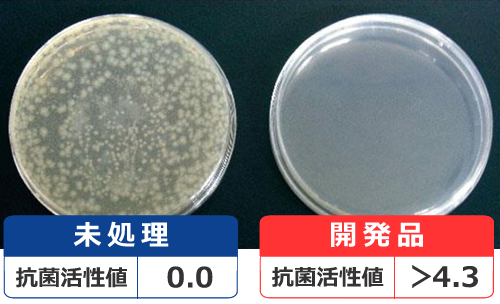
菌A

室内抗菌加工サービス

大阪府吹田市・北摂のハウスクリーニング
ダスキンスウィング
【サービス中心エリア】大阪府内全域(一部お伺いできない地域もございます。)
ダスキンの抗菌コーティング
衛生面の対策に不安を感じておられる方へ

事業所の衛生と安心をサポート!
複数の人の手が触れる箇所も、1回の施工で効果が長持ち。
日常のお手入れがラクになる抗菌サービスはいかがですか?
こんなお悩みありませんか?

- お客様やスタッフに安心してもらいたい。
- 従業員による毎日の消毒作業が大変。
- 人が出入りする箇所の感染リスクを減らしたい。

事務所やエントランスの電話機

飲食店のテーブル

入口や各室のドアノブ

壁紙(ビニールクロス)

ソファ

バス・電車・タクシーの座席
ダスキンの室内抗菌加工サービス
複数の人の手がよく触れる箇所はもちろん、壁紙やソファなど軟らかい素材にも対応!
2通りの抗菌加工サービスをご提供いたします。
1.硬質面施工

1日2回清掃しても、約6ヵ月効果が持続!
「業務が忙しくて掃除ができない」「消毒をひんぱんにできない」
そんなお困りごとやご要望にお応えするために、ダスキンでは接触頻度の高い箇所に抗菌効果のある硬質面コーティング剤を施工いたします。
| 標準料金 | 33,000円(税込) |
|---|
- 施工対象面積:合計20㎡まで一律
- 20㎡を超える場合は、20㎡毎に33,000円(税込)追加
【硬質面】抗菌加工サービスの特長

- 抗菌持続性が高い
- クリアな仕上がりで外観を損なわない
- 人がよく触れる箇所の部分対応が可能
- 日常のお手入れがラクに
- 施工後には実施済みシールを貼付
サービス実施個所の例





特殊抗菌成分を被膜とともに固定化
することで抗菌効果が持続
360回の耐久テスト後も抗菌効果が持続!
抗菌耐久性試験
1日2回の清掃を行っても、約6ヵ月抗菌効果が持続。
荷重500gで360往復の水拭き後に、抗菌試験JIS Z 2801で評価。
- 1日2回、同じ個所を1往復清掃するとして約6ヵ月相当。
- 汚れがひどい場合はアルコール、中性・弱アルカリ性の洗剤も使用可能です。
抗菌活性値2.0以上を確認
コーティング剤に含まれる特殊抗菌成分が菌の繁殖を抑制し、抗菌効果を発揮します。
[24時間後の試験結果]JIS Z 2801 抗菌試験による
食品衛生法の基準をクリアしたコーティング剤を使用。
施工後、人体に有害な物質は溶け出しません。
菌A
菌B

【硬質面施工】標準料金
| 標準料金 | 33,000円(税込) |
|---|
- 施工対象面積:合計20㎡まで一律
- 20㎡を超える場合は、20㎡毎に33,000円(税込)追加
- すべての菌に効果があるわけではありません。
- 使用状況、使用環境により効果の持続期間は異なります。(メーカー調べ)
- 料金は消費税(10%)込みの総額表示となっています。
- 消費税の円未満の端数処理により、表示料金と領収金額が異なる場合がございます。
- 商品・サービスは、予告なしに内容、使用、料金の変更や販売を中止することがございますのでご了承ください。
- サービスカーの駐車スペースのご用意をお願いします。駐車できない場合は有料駐車場を利用するため、駐車料金をご負担いただきます。
- 写真、イラストはイメージです。
2.光触媒施工

スプレーガン
コンプレッサー

ローラー
抗菌成分が付着している限り効果は持続!
天井や壁、繊維など硬質面以外の箇所への抗菌加工サービスです。
抗菌・抗ウィルス・消臭をはじめ、シックハウス症候群の原因となる有害物質の低減も可能にし、効果は成分が付着している限り持続します。
- ソファーや座席など、よく触れる箇所は1年に1回の施工がおすすめです。
| 標準料金 | 2,200円(税込)/1㎡あたり |
|---|
サービス実施個所の例








光触媒施工の特長

- 抗菌
大腸菌や黄色ブドウ球菌など、病院や介護施設で問題視される菌を分解。抗菌成分が付着している限り、効果が持続します。 - 抗ウイルス
人、鶏、豚インフルエンザやノロウイルス等のウイルスを分解します。 - 消臭
タバコ臭、ペット臭、アンモニア臭などの生活臭を分解します。 - VOC(総揮発性有機化合物)低減
シックハウス症候群の原因となる有害化学物質を分解します。 - 室内のあかりで効果を発揮
紫外線がないと作用しない一般の光触媒とは異なり、室内のあかりで効果を発揮します。
光触媒に光が当たると、光を吸収して周囲の水分子などをラジカル化します。
このラジカルがウイルスや細菌などにアタックすることで、酸化分解し、抗菌機能を発揮します。


酸化分解します。
光触媒施工 よくある質問
効果はどのくらい持続しますか。
抗菌成分が施工面に付着している限り、効果は持続します。

しかしながら、アルカリ洗剤で掃除をしたり強く拭くと抗菌成分がなくなってしまいます。
2~3年で再施工することをおすすめします。
アルコール拭きやオゾンでの除菌と何が違いますか。
アルコールやオゾンは瞬時に効果を発揮しますが、効果は持続しません。

対して光触媒は、施工した直後から分解が始まり効果を発揮するとともに、継続的な効果も期待できます。
施工後はどんなお手入れをすればいいですか。
基本的には必要ありません。

ホコリが積もったら掃除機をかけるか、乾いた雑巾で拭いてください。
油性の油が付着した場合は、清掃後に再施工することをおすすめします。
また、アルカリ性洗剤を使用すると光触媒自体が溶けてしまいますので、乾拭きで除去できない汚れは固く絞った水拭きや中性洗剤で拭き上げます。
乳幼児が使う布に使っても大丈夫ですか?
口にしたり舐める可能性のあるものへの使用はお控えください。

光触媒の安全性検証データの検討結果では、特に問題は考えられませんが、個人差により異常を感じることが考えられますので、乳幼児が口にしたり、舐める可能性のあるものへの使用はお控えください。
犬や猫が、施工された部分を舐めても大丈夫ですか。
安全上の問題は特に考えられません。

光触媒の安全性検証データの検討結果から、注意書きに従って正しくご使用いただいた場合、安全性上の問題は特に考えられません。異常な症状が現れたり、継続する場合は獣医師にご相談ください。
【光触媒施工】標準料金
| 標準料金 | 2,200円(税込)/1㎡あたり |
|---|
- すべての菌に効果があるわけではありません。
- 使用状況、使用環境により効果の持続期間は異なります。(メーカー調べ)
- 料金は消費税(10%)込みの総額表示となっています。
- 消費税の円未満の端数処理により、表示料金と領収金額が異なる場合がございます。
- 商品・サービスは、予告なしに内容、使用、料金の変更や販売を中止することがございますのでご了承ください。
- サービスカーの駐車スペースのご用意をお願いします。駐車できない場合は有料駐車場を利用するため、駐車料金をご負担いただきます。
- 写真、イラストはイメージです。
メールでのお申込み・お問い合わせフォーム
以下のフォームに必要事項をご記入の上、「送信する」ボタンをクリックしてください。


